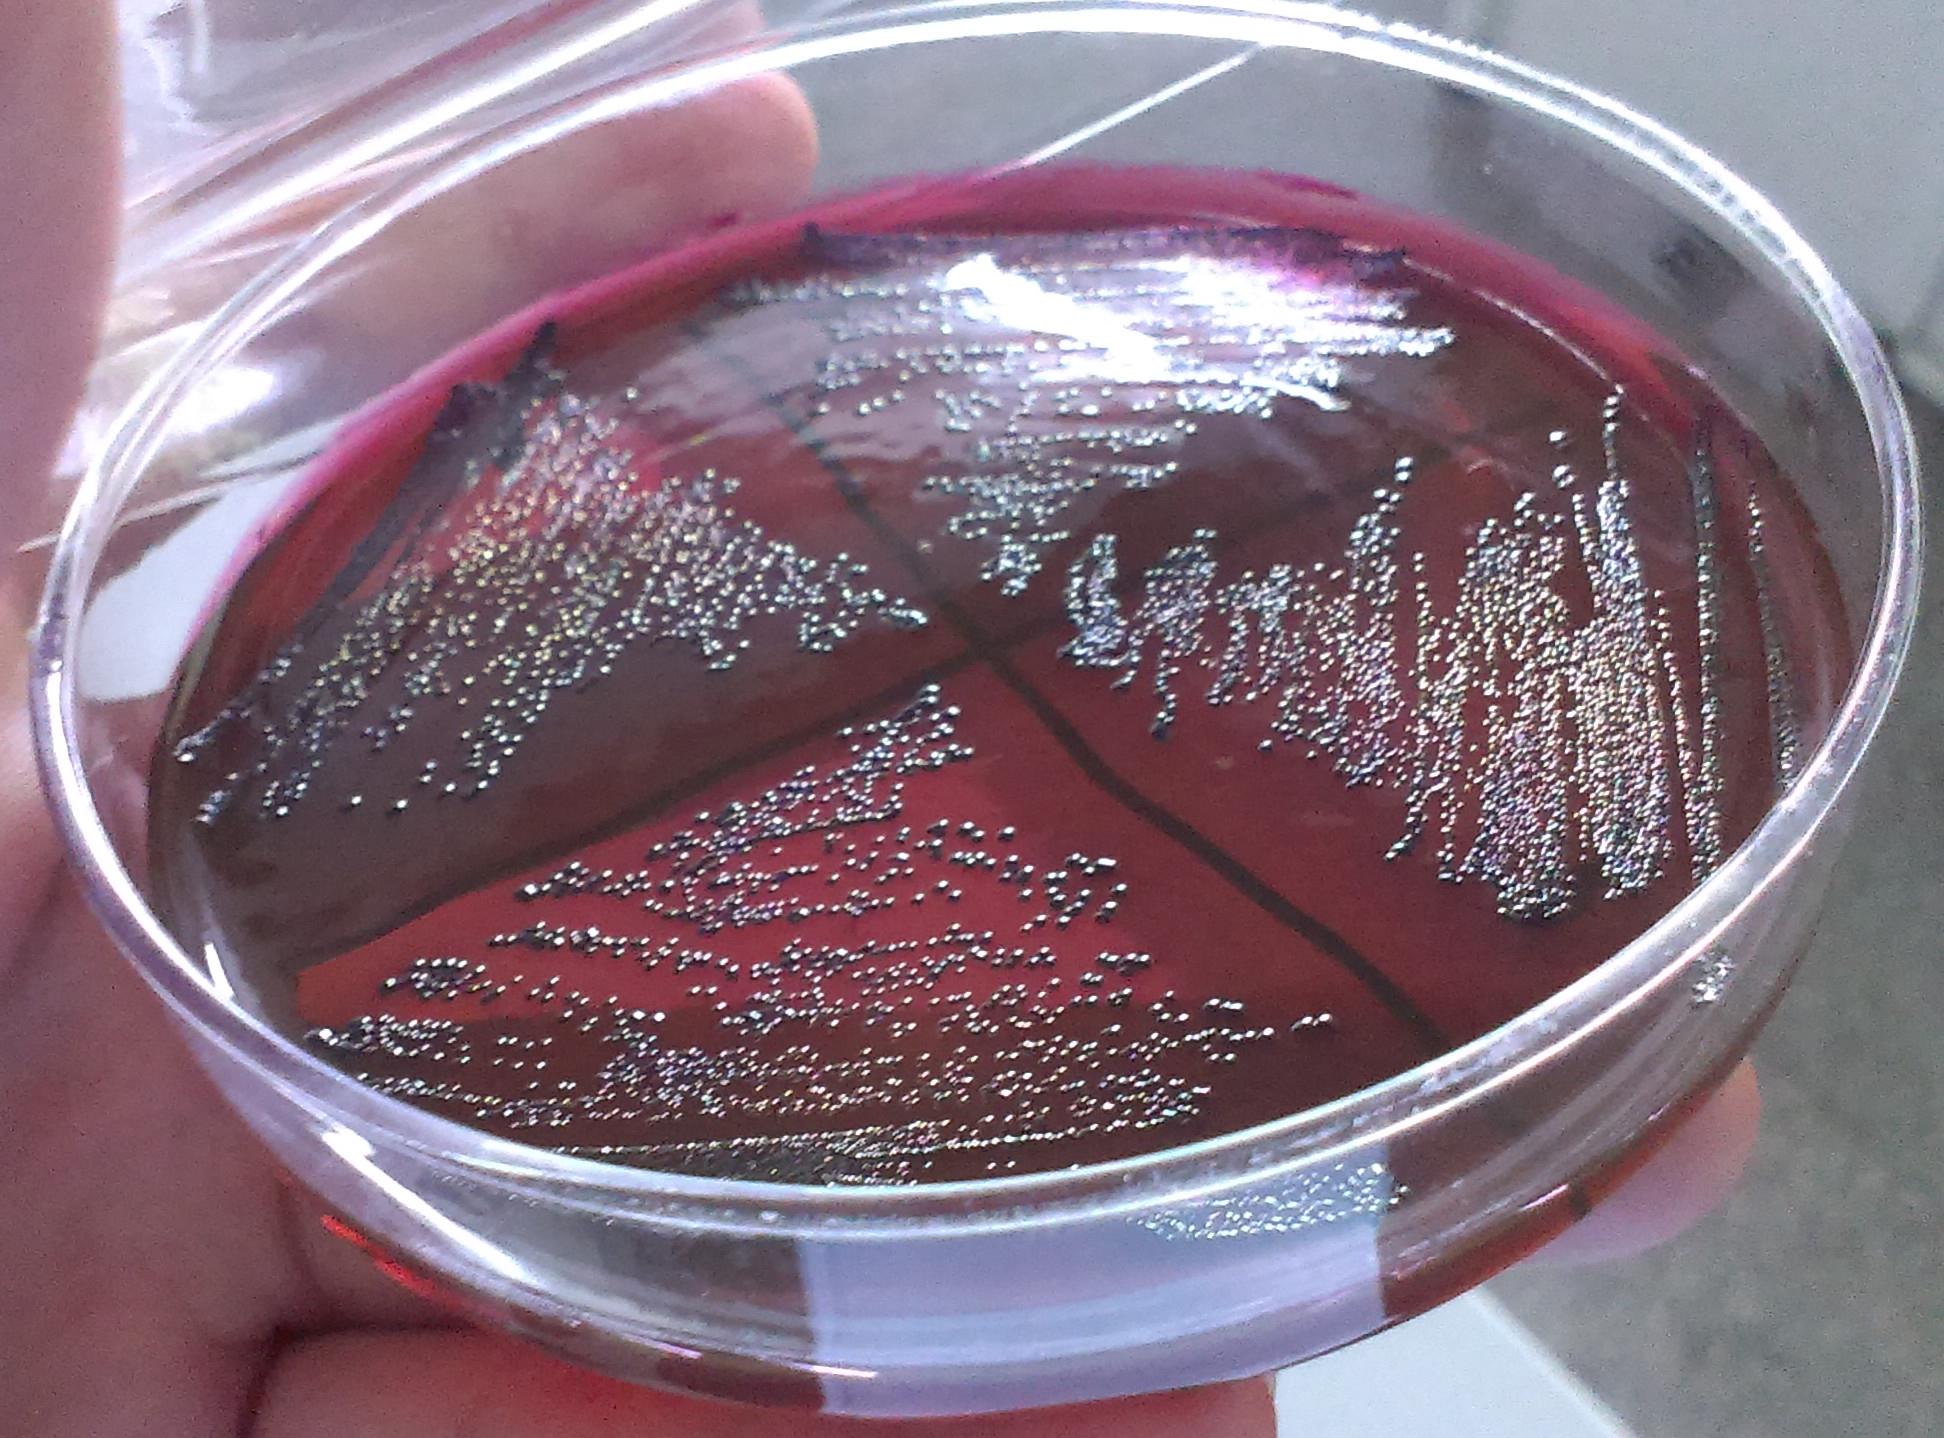
细菌都是什么颜色的?一种细菌长在不同的营养物质上颜色一样吗?

细菌颜色

常见菌种—马拉色菌.
图片尺寸994x1171
细菌都是什么颜色的?一种细菌长在不同的营养物质上颜色一样吗?
图片尺寸1944x1438
革兰染色细菌微生物玻片10种25种50种高教标准制作球菌杆菌螺旋菌
图片尺寸750x488
细菌色卡09
图片尺寸772x960
jpg颜色:rgb40共享分举报收藏立即下载×关 键 词:细菌 微生物 入侵
图片尺寸1024x1024
大五颜六色的设置与不同的危险和细菌的名称. 微生物学教育的矢量插图
图片尺寸700x700
jpg颜色:rgb40共享分举报收藏立即下载×关 键 词:细菌 微生物 入侵
图片尺寸1024x1024
jpg颜色:rgb40共享分举报收藏立即下载关 键 词:细菌 微观世界 病菌
图片尺寸1024x1024
jpg颜色:rgb40共享分举报收藏立即下载关 键 词:微生物 细菌 病原体
图片尺寸1023x1024
细菌纹理图片
图片尺寸450x300
刷牙很重要!看口腔细菌在显微镜下的模样吧
图片尺寸950x816
jpg颜色:rgb30共享分举报收藏立即下载×关 键 词:细菌 医疗 微生物
图片尺寸1024x683
微生物染色解析你知道这些细菌的颜色吗
图片尺寸600x433
细菌的种类多种多样.
图片尺寸693x437
细菌照片
图片尺寸450x300
生物专家用培养皿画画,画成的细菌作品,色彩炸裂
图片尺寸640x640
细菌总数显色平板9cm(2-8℃)
图片尺寸628x624
不同颜色的细菌
图片尺寸1200x722
不同颜色的细菌
图片尺寸1180x1100
细菌,细胞,革兰氏染色阳性,球菌,链子,医疗,背景
图片尺寸525x350